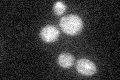
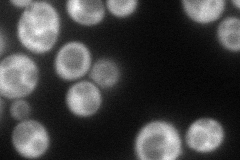
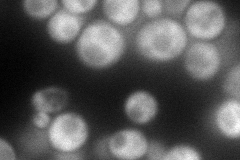
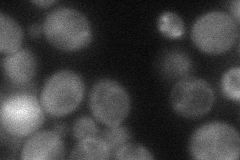
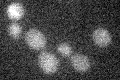

View description
One of two large regulatory subunits of ribonucleotide-diphosphate reductase; the RNR complex catalyzes rate-limiting step in dNTP synthesis, regulated by DNA replication and DNA damage checkpoint pathways via localization of small subunits
Localization:
Intensity:
Fold change:
Significance:
-
C’ GFP library in SD
cytosol19.68 -
N' NOP1pr-GFP in SD
cytosol90.6187 -
N' TEF2pr-mCherry in SD
cytosol103.009 -
N' NATIVEpr-GFP in SD

cytosol132.531 -
N' TEF2pr-VC and Cyto-VN in SD
cytosol47.6135 -
C’ GFP library in SD+DTT

cytosol13.010.66No -
C’ GFP library in SD+H2O2

cytosol18.380.93No -
C’ GFP library in Starvation Media
cytosol14.510.73No -
C’ GFP library on the background of Pup2-DaMP

cytosol -
C’ GFP library on the background of CCT mutant

cytosol19.55820.993052No
